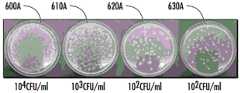

CN112877802A - Antibacterial fiber - Google Patents
Antibacterial fiberDownload PDFInfo
- Publication number
- CN112877802A CN112877802ACN201911202188.7ACN201911202188ACN112877802ACN 112877802 ACN112877802 ACN 112877802ACN 201911202188 ACN201911202188 ACN 201911202188ACN 112877802 ACN112877802 ACN 112877802A
- Authority
- CN
- China
- Prior art keywords
- antimicrobial
- ldpe
- fiber
- ultra
- high molecular
- Prior art date
- Legal status (The legal status is an assumption and is not a legal conclusion. Google has not performed a legal analysis and makes no representation as to the accuracy of the status listed.)
- Pending
Links
Images
Classifications
- D—TEXTILES; PAPER
- D01—NATURAL OR MAN-MADE THREADS OR FIBRES; SPINNING
- D01F—CHEMICAL FEATURES IN THE MANUFACTURE OF ARTIFICIAL FILAMENTS, THREADS, FIBRES, BRISTLES OR RIBBONS; APPARATUS SPECIALLY ADAPTED FOR THE MANUFACTURE OF CARBON FILAMENTS
- D01F8/00—Conjugated, i.e. bi- or multicomponent, artificial filaments or the like; Manufacture thereof
- D01F8/04—Conjugated, i.e. bi- or multicomponent, artificial filaments or the like; Manufacture thereof from synthetic polymers
- D01F8/06—Conjugated, i.e. bi- or multicomponent, artificial filaments or the like; Manufacture thereof from synthetic polymers with at least one polyolefin as constituent
- D—TEXTILES; PAPER
- D01—NATURAL OR MAN-MADE THREADS OR FIBRES; SPINNING
- D01F—CHEMICAL FEATURES IN THE MANUFACTURE OF ARTIFICIAL FILAMENTS, THREADS, FIBRES, BRISTLES OR RIBBONS; APPARATUS SPECIALLY ADAPTED FOR THE MANUFACTURE OF CARBON FILAMENTS
- D01F6/00—Monocomponent artificial filaments or the like of synthetic polymers; Manufacture thereof
- D01F6/44—Monocomponent artificial filaments or the like of synthetic polymers; Manufacture thereof from mixtures of polymers obtained by reactions only involving carbon-to-carbon unsaturated bonds as major constituent with other polymers or low-molecular-weight compounds
- D01F6/46—Monocomponent artificial filaments or the like of synthetic polymers; Manufacture thereof from mixtures of polymers obtained by reactions only involving carbon-to-carbon unsaturated bonds as major constituent with other polymers or low-molecular-weight compounds of polyolefins
- D—TEXTILES; PAPER
- D01—NATURAL OR MAN-MADE THREADS OR FIBRES; SPINNING
- D01D—MECHANICAL METHODS OR APPARATUS IN THE MANUFACTURE OF ARTIFICIAL FILAMENTS, THREADS, FIBRES, BRISTLES OR RIBBONS
- D01D10/00—Physical treatment of artificial filaments or the like during manufacture, i.e. during a continuous production process before the filaments have been collected
- D01D10/02—Heat treatment
- D—TEXTILES; PAPER
- D01—NATURAL OR MAN-MADE THREADS OR FIBRES; SPINNING
- D01D—MECHANICAL METHODS OR APPARATUS IN THE MANUFACTURE OF ARTIFICIAL FILAMENTS, THREADS, FIBRES, BRISTLES OR RIBBONS
- D01D5/00—Formation of filaments, threads, or the like
- D01D5/06—Wet spinning methods
- D—TEXTILES; PAPER
- D01—NATURAL OR MAN-MADE THREADS OR FIBRES; SPINNING
- D01D—MECHANICAL METHODS OR APPARATUS IN THE MANUFACTURE OF ARTIFICIAL FILAMENTS, THREADS, FIBRES, BRISTLES OR RIBBONS
- D01D5/00—Formation of filaments, threads, or the like
- D01D5/12—Stretch-spinning methods
- D01D5/16—Stretch-spinning methods using rollers, or like mechanical devices, e.g. snubbing pins
- D—TEXTILES; PAPER
- D01—NATURAL OR MAN-MADE THREADS OR FIBRES; SPINNING
- D01F—CHEMICAL FEATURES IN THE MANUFACTURE OF ARTIFICIAL FILAMENTS, THREADS, FIBRES, BRISTLES OR RIBBONS; APPARATUS SPECIALLY ADAPTED FOR THE MANUFACTURE OF CARBON FILAMENTS
- D01F1/00—General methods for the manufacture of artificial filaments or the like
- D01F1/02—Addition of substances to the spinning solution or to the melt
- D01F1/10—Other agents for modifying properties
- D01F1/103—Agents inhibiting growth of microorganisms
- D—TEXTILES; PAPER
- D01—NATURAL OR MAN-MADE THREADS OR FIBRES; SPINNING
- D01F—CHEMICAL FEATURES IN THE MANUFACTURE OF ARTIFICIAL FILAMENTS, THREADS, FIBRES, BRISTLES OR RIBBONS; APPARATUS SPECIALLY ADAPTED FOR THE MANUFACTURE OF CARBON FILAMENTS
- D01F6/00—Monocomponent artificial filaments or the like of synthetic polymers; Manufacture thereof
- D01F6/02—Monocomponent artificial filaments or the like of synthetic polymers; Manufacture thereof from homopolymers obtained by reactions only involving carbon-to-carbon unsaturated bonds
- D01F6/04—Monocomponent artificial filaments or the like of synthetic polymers; Manufacture thereof from homopolymers obtained by reactions only involving carbon-to-carbon unsaturated bonds from polyolefins
- D—TEXTILES; PAPER
- D10—INDEXING SCHEME ASSOCIATED WITH SUBLASSES OF SECTION D, RELATING TO TEXTILES
- D10B—INDEXING SCHEME ASSOCIATED WITH SUBLASSES OF SECTION D, RELATING TO TEXTILES
- D10B2321/00—Fibres made from polymers obtained by reactions only involving carbon-to-carbon unsaturated bonds
- D10B2321/02—Fibres made from polymers obtained by reactions only involving carbon-to-carbon unsaturated bonds polyolefins
- D10B2321/021—Fibres made from polymers obtained by reactions only involving carbon-to-carbon unsaturated bonds polyolefins polyethylene
- D10B2321/0211—Fibres made from polymers obtained by reactions only involving carbon-to-carbon unsaturated bonds polyolefins polyethylene high-strength or high-molecular-weight polyethylene, e.g. ultra-high molecular weight polyethylene [UHMWPE]
- D—TEXTILES; PAPER
- D10—INDEXING SCHEME ASSOCIATED WITH SUBLASSES OF SECTION D, RELATING TO TEXTILES
- D10B—INDEXING SCHEME ASSOCIATED WITH SUBLASSES OF SECTION D, RELATING TO TEXTILES
- D10B2401/00—Physical properties
- D10B2401/13—Physical properties anti-allergenic or anti-bacterial
Landscapes
- Engineering & Computer Science (AREA)
- Textile Engineering (AREA)
- Chemical & Material Sciences (AREA)
- Chemical Kinetics & Catalysis (AREA)
- General Chemical & Material Sciences (AREA)
- Mechanical Engineering (AREA)
- Physics & Mathematics (AREA)
- Thermal Sciences (AREA)
- Manufacturing & Machinery (AREA)
- Artificial Filaments (AREA)
- Knitting Of Fabric (AREA)
- Spinning Methods And Devices For Manufacturing Artificial Fibers (AREA)
Abstract
Translated fromChineseDescription
Technical Field
Exemplary embodiments of the present application relate generally to high performance materials, and more particularly to antimicrobial high performance material structures and composites.
Background
Most personal protective equipment typically consists of a fabric that is not antimicrobialPerformance of ultra-high molecular weight polyethylene. Ultra-high molecular weight polyethylene is often located near the skin and can become itchy and/or emit an unpleasant odor due to bacterial growth. Current methods of producing antimicrobial materials include dipping gloves into antimicrobial additives, such as Ag and Ag+Quaternary ammonium compounds or other agents. However, the antimicrobial properties of the impregnated material are non-permanent and add an additional step to the manufacture of the glove. Furthermore, the antibacterial and life span of the impregnated material typically varies from material to material. In addition, the process is complicated and contamination occurs in order to produce antibacterial materials.
Applicants have identified a number of drawbacks and problems associated with high performance material structural data. Through efforts, creations, and innovations, many of these identified problems have been solved by developing solutions included in embodiments of the present disclosure, many examples of which are described in detail herein.
Disclosure of Invention
Exemplary embodiments of the present disclosure relate to a cut-resistant highly antibacterial fibrous structure and related methods of manufacture. In one exemplary embodiment, an antimicrobial fiber is provided. The antimicrobial fibers comprise an ultra-high molecular weight polyethylene structure. The antimicrobial fiber further comprises an antimicrobial Low Density Polyethylene (LDPE). The antimicrobial LDPE comprises polyhexamethylene guanidine (PHMG) grafted onto the LDPE structure. The ultra-high molecular weight polyethylene structure and the antimicrobial LDPE are combined together to form the antimicrobial fiber.
In some embodiments, the antimicrobial low density polyethylene is dissolved in oil. In some embodiments, the oil that dissolves the antimicrobial low density polyethylene comprises coal oil (coal oil). In some embodiments, the weight of the antimicrobial LDPE is about 1% of the total weight of the antimicrobial fiber. In some embodiments, the ultra high molecular weight polyethylene and the antimicrobial LDPE are combined using gel spinning. In some embodiments, the weight of the antimicrobial LDPE is from 0.5% to 10% of the total weight of the antimicrobial fiber.
In some embodiments, the ultra high molecular weight polyethylene structure is extruded through an extrusion apparatus. In some embodiments, the ultra high molecular weight polyethylene structure is extruded through an extrusion apparatus prior to being combined with the antimicrobial LDPE. In some embodiments, the ultra high molecular weight polyethylene structure and the antimicrobial LDPE are extruded through a flow regulating device (modulated flow device). In some embodiments, the antimicrobial fibers can be configured as a garment material.
In another exemplary embodiment, a method of making an antimicrobial fiber is provided. The method includes adding an ultra-high molecular weight polyethylene structure to an extrusion apparatus. The method further includes feeding antimicrobial Low Density Polyethylene (LDPE) into the ultra high molecular weight polyethylene at a predetermined temperature to produce combined filaments (filamentt). The method further comprises passing the combined filaments through a bath. The bath is configured to coagulate (coagulating) the combined filaments and extract the solvent. The method still further includes drying the combined filaments through an oven. The process further comprises hot-drawing (hot-drawing) the combined filaments. Heating the combined filaments within the oven during the hot drawing and the resulting combined filaments have antimicrobial properties.
In some embodiments, the predetermined temperature is about 80 degrees celsius to 200 degrees celsius. In some embodiments, the predetermined temperature is about 105 degrees celsius. In some embodiments, the antimicrobial LDPE supplied to the extruded ultra-high molecular weight polyethylene is dissolved into oil. In some embodiments, the oil that dissolves the antimicrobial low density polyethylene comprises coal oil. In some embodiments, the weight of the antimicrobial LDPE is about 1% of the total weight of the antimicrobial fiber. In some embodiments, the weight of the antimicrobial LDPE is from 0.5% to 10% of the total weight of the antimicrobial fiber.
In some embodiments, the method further comprises extruding the ultra-high molecular weight polyethylene structure and the antimicrobial LDPE through a flow regulating apparatus. In some embodiments, the high density polyethylene is extruded through an extrusion apparatus prior to being combined with the antimicrobial LDPE. In some embodiments, the method further comprises threading (threading) the antimicrobial fibers together to form an antimicrobial garment material.
The above summary is provided merely to summarize some example embodiments to provide a basic understanding of some aspects of the present invention. Therefore, it will be understood that the above-described embodiments are merely examples and should not be construed as limiting the scope or spirit of the invention in any way. It will be understood that the scope of the present invention includes many possible embodiments in addition to those outlined herein, some of which are described further below.
Drawings
Having thus described certain exemplary embodiments of the present disclosure in general terms, reference will now be made to the accompanying drawings. The components shown in the figures may or may not be present in certain embodiments described herein. Some embodiments may include fewer (or more) components than those shown in the figures.
FIG. 1 illustrates an exemplary antimicrobial fibrous structure of the present disclosure implemented in an exemplary antimicrobial glove;
fig. 2 illustrates an exemplary antimicrobial low density polyethylene produced by grafting PHMG to a low density polyethylene to be used in combination with other polyethylene structures, according to an exemplary embodiment of the present disclosure;
FIG. 3 illustrates a simplified manufacturing process for producing antimicrobial fibers according to the present disclosure;
FIG. 4 is a flow chart illustrating an exemplary method of making antimicrobial fibers according to an exemplary embodiment of the present disclosure;
FIG. 5 illustrates an exemplary method of making an antimicrobial fiber, such as the method discussed in FIG. 4, according to an exemplary embodiment of the present disclosure; and
fig. 6A and 6B show bacterial accumulation of high performance polyethylene fibers without (fig. 6A) and with (fig. 6B) antimicrobial LDPE, according to an exemplary embodiment.
Detailed Description
SUMMARY
The present inventions now will be described more fully hereinafter with reference to the accompanying drawings, in which some, but not all embodiments of the inventions are shown. Indeed, these inventions may be embodied in many different forms and should not be construed as limited to the embodiments set forth herein; rather, these embodiments are provided so that this disclosure will satisfy applicable legal requirements. Like numbers refer to like elements throughout. As used herein, terms such as "front," "back," "top," and the like are used in the examples provided below for illustrative purposes to describe the relative position of certain components or portions of components. Further, it will be apparent to those of ordinary skill in the art in light of the present disclosure that the terms "substantially" and "about" mean that the referenced elements or associated description are accurate within applicable engineering tolerances.
The term "comprises/comprising/includes" means including/including but not limited to, and should be interpreted in the manner in which it is commonly used in a patent environment. The phrases "in one embodiment," "according to one embodiment," and the like generally mean that a particular feature, structure, or characteristic following the phrase may be included in at least one embodiment of the invention, and may be included in more than one embodiment of the invention (importantly, such phrases do not necessarily refer to the same embodiment). If the specification describes something as "exemplary" or an "example," it should be understood to refer to a non-exclusive example.
As discussed herein, exemplary embodiments may be described with reference to fibrous structures comprising various cores, filaments, yarns, coverings, and the like. In this regard, in some examples, the described and claimed fiber structures may be referred to as composite fiber structures. For clarity of description, exemplary embodiments of the present application are described herein with reference to "antimicrobial fibers," but may equally and interchangeably refer to composite antimicrobial fiber structures. The term antimicrobial may refer to a substantial reduction of bacteria, may refer to a complete reduction and/or elimination of bacteria, may refer to fibers active against bacteria, and/or the like. Various embodiments of the present disclosure enable materials with antimicrobial properties to be obtained without expensive manufacturing and/or additional steps (e.g., coating, etc.). For example, some gloves currently use the antimicrobial coating of traditional gloves to reduce bacteria, but this method is not but not permanent and adds an extra step to the manufacturing process.
Referring to fig. 1, anantimicrobial glove 100 embodying and/or consisting of an exemplary antimicrobial fiber is shown. As shown,antimicrobial glove 100 may be manufactured or formed from antimicrobial fibers manufactured according to one exemplary embodiment discussed herein. For example, the antimicrobial fibers may be used to produce yarns for use in the manufacture of antimicrobial fabrics configured for use in apparel fabrics and the like.
As described below with reference to fig. 3-5, the antimicrobial fibers of the present application can be produced from a combination of a high density polyethylene, such as an ultra-high molecular weight polyethylene (UHMWPE) starting material, and an antimicrobial Low Density Polyethylene (LDPE) (e.g., formed from PHMG grafted with LDPE). While the present disclosure may refer to high density polyethylene in connection with UHMWPE, other high density polyethylene structures are also contemplated.
Although discussed primarily with reference to gel spinning, the high density polyethylene and the antimicrobial LDPE can be combined using various spinning techniques such as dry spinning, wet spinning, and the like. Although illustrated and described with reference to an antimicrobial fibrous structure used to formantimicrobial glove 100, the present disclosure contemplates that the antimicrobial fibrous structure described herein can be used to form any garment (e.g., pants, shirts, jackets, coverings, etc.) as well, without limitation. In some embodiments, the antimicrobial fibers can have a light color (e.g., the antimicrobial fibers can be light yellow) such that the antimicrobial fibers can be dyed various colors for use.
Referring now to fig. 2, an exemplary antimicrobial LDPE is shown, according to an exemplary embodiment. As shown, PHMG is grafted onto LDPE to form theantimicrobial LDPE 200 discussed herein. In various embodiments, the PHMG structure can be (C)7H15N3)nAnd can be configured to be grafted to LDPE to produce the antimicrobial LDPE structures discussed herein.
Referring now to fig. 3, a simplified method of making an antimicrobial fiber is shown. As shown, the antimicrobial fiber discussed above with reference to fig. 1 can be manufactured by gel spinning UHMWPE raw material and antimicrobial LDPE (i.e., PHMG-grafted LDPE) to produce antimicrobial UHMWPE filaments (e.g., the antimicrobial fiber). In some embodiments, the amount of antimicrobial LDPE can vary based on the amount of antimicrobial desired, the cost desired, and the like. In some embodiments, the antimicrobial LDPE may be about 0.5% to 10% of the total weight of the antimicrobial fiber. In some embodiments, the antimicrobial LDPE may be about 0.75% to 3% of the total weight of the antimicrobial fiber. In some embodiments, the antimicrobial LDPE may be about 0.8% to 1.5% of the total weight of the antimicrobial fiber. In some embodiments, the antimicrobial LDPE may be about 1% of the total weight of the antimicrobial fiber.
FIG. 4 illustrates an exemplary method of manufacture according to an exemplary embodiment. Unless explicitly stated otherwise, various embodiments of the described methods may be performed in a different order than described herein. Additional operations may also be included during the process of making the antimicrobial fiber, and thus the following steps are not exhaustive.
Referring now to block 400 of FIG. 4, the method of manufacturing includes blending ultra-high molecular weight polyethylene (e.g., having a 1 × 10 density)6-2×107A viscosity average molecular weight polyethylene in grams/mole) structure is added to the extrusion equipment. In some embodiments, the UHMWPE may be added to the extrusion apparatus using a mixing vessel or the like. In some embodiments, the mixing vessel may include an agitator (e.g., an agitator blade, etc.). In some embodiments, the UHMWPE may be combined with one or more additional substances (e.g., the UHMWPE may be suspended in a first solvent, such as white oil (white oil) or chlorofluoroalkane, and in some cases, additional substances, such as surfactants, dispersants) to form an UHMWPE solution to aid in the extrusion process. In various embodiments, the UHMWPE structure may be suspended in a non-volatile first solvent at a given concentration. In some embodiments, the UHMWPE concentration may be between about 5% and 20% of the UHMWPE solution, preferably between about 6% and 15% of the UHMWPE solution, morePreferably about 8% of the UHMWPE solution. In various embodiments, theextrusion apparatus 510 may be a twin screw configured to rotate during operation. In some embodiments, theextrusion apparatus 510 may also heat the UHMWPE raw material during operation.
Referring now to block 410 of fig. 4, the manufacturing process includes feeding coal oil with antimicrobial LDPE into extruded high density polyethylene. In some embodiments, the antimicrobial LDPE added may be about 0.5% to 3%, preferably about 0.75% to 2%, more preferably about 1% of the total weight of the combined filaments. In some embodiments, the antimicrobial LDPE solution may be added to the UHMWPE solution. For example, in the case where coal distillate oil is then added to extruded UHMWPE at a predetermined temperature, the antimicrobial LDPE may be dissolved in the coal distillate oil.
In some examples, coal oil with antimicrobial LDPE can be added to UHMWPE at a predetermined temperature. In some embodiments, the predetermined temperature of the UHMWPE when the antimicrobial LDPE is added may be about 80 to 200 degrees celsius, preferably about 80 to 160 degrees celsius, more preferably about 105 degrees celsius. In some embodiments, the coal oil can be a shale oil, such as kerosene (kerosene). In some embodiments, other solvent materials may be used to dissolve the antimicrobial LDPE, such as decalin.
Referring now to block 420 of fig. 4, the manufacturing process includes processing the combined filaments using aflow regulating device 530. In various embodiments, theflow conditioning apparatus 530 may be configured to extrude the combined filaments. In some embodiments, theflow conditioning apparatus 530 can be in communication with aspinneret 540, thespinneret 540 configured to separate the combined filaments into a plurality of filaments or fibers once the combined filaments are extruded. The extrusion speed and subsequent processing through thespinneret 540 can be based on the type of application, the equipment used, the size of the desired fibers, and/or the like. In some embodiments, the filaments or fibers produced by thespinneret 540 continue through thebath 550 to solidify.
Referring now to block 430 of fig. 4, the manufacturing process includes passing the combined filaments through abath 550. In various embodiments, thebath 550 may act as a coagulation bath such that the combined filaments may be quenched (e.g., the polymer chains of the combined filaments may be quenched). In various embodiments, thebath 550 may comprise a quenching liquid, such as water. In some embodiments, the quench liquid in thebath 550 may be ambient temperature water (e.g., approximately 20 to 30 degrees celsius). In some embodiments,bath 550 may comprise a second solvent, e.g., xylene, dichloromethane. In various embodiments, the second solvent may be used to extract the first solvent from the combined filaments. In various embodiments, the first solvent may be extracted withinbath 550. In some embodiments, the combined filaments may also undergo cold drawing withinbath 550. For example, thebath 550 may have one or more rollers configured to feed the combined filaments through thebath 550. In some embodiments, the one or more rollers may operate with little to no tension on the combined filaments.
Referring now to block 440 of fig. 4, the manufacturing process includes providing heat to the combined filaments through anoven 560. In various embodiments, after the combined filaments pass throughbath 550 such that the fibers are quenched and the first solvent is removed, the fibers may then enter anoven 560 configured to provide heat to the fibers. In various embodiments,oven 560 can be configured to remove a portion (e.g., a majority) of the second solvent from the fibers during the drying process. In various embodiments,oven 560 can be a dedicated oven configured for the processes described herein. In some embodiments,oven 560 can be a convection oven.
Referring now to block 450 of fig. 4, the manufacturing process includes hot drawing the filament fibers through anoven 560. In some embodiments, the hot stretching may be divided into multiple stages. For example, the hot drawing may be divided into three stages or stretches such that each stretch uses rollers within an oven to redirect the combined filaments. In various embodiments, the desired amount of heat applied to the fibers may affect the number of stretches. In various embodiments, the stretching temperature may be in the range of about 110 degrees celsius to 200 degrees celsius, preferably about 110 degrees celsius to 160 degrees celsius, and more preferably about 140 degrees celsius.
Referring now to block 460 of fig. 4, the manufacturing method includes winding the finished antimicrobial fiber 570 onto a spool (e.g., a reel). In this embodiment, the antimicrobial fiber is to be used, for example, in theantimicrobial glove 100 shown in fig. 1. In various embodiments, the finished antimicrobial fiber may be used in a manner similar to other fibers currently in use. For example, the antimicrobial fibers may be used in a variety of applications, such as gloves (e.g., antimicrobial glove 100), shoe upper (upper skin) materials, apparel fabrics, cords, and/or the like. Further, the antimicrobial fibers can be configured to have antimicrobial properties without any additional manufacturing steps (e.g., the antimicrobial fibers themselves have antimicrobial properties and do not require additional coating).
Exemplary manufacturing method
As shown in fig. 5, the UHMWPE structure may be added to anextrusion apparatus 510 that extrudes UHMWPE suspended in a first solvent via twin screws or the like. The antimicrobial LDPE can be added to the high density polyethylene at a predetermined temperature, for example at about 110 degrees celsius. In some embodiments, theantimicrobial LDPE 200 may be dissolved in anoil 500, such as coal distillate oil. In some embodiments,oil 500 with dissolvedantimicrobial LDPE 200 may be combined with UHMWPE atpoint 520. Once combined, the combined filaments can be passed through aflow conditioning device 530, which flowconditioning device 530 extrudes the combined filaments and transfers the combined filaments to aspinneret 540 configured to separate the combined filaments into individual filaments. After the individual filaments have been produced by thespinneret 540, the combined filaments may then enter abath 550, whichbath 550 acts as a coagulation bath (e.g., water in the bath that quenches the combined filaments) and an extraction bath (e.g., a second solvent present in the bath to extract the first solvent). In various embodiments, the combined filaments may undergo cold drawing withinbath 550. In some embodiments, the combined filaments may pass through anoven 560 to dry the combined filaments, thereby evaporating the second solvent. Further, within theoven 560, the filament fibers may undergo thermal stretching (e.g., to achieve high orientation and high crystallinity of the polymer chains) before being wound to serve as the antimicrobial fibers 570.
Exemplary antibacterial test results
Fig. 6A-6B show bacterial reduction from a typical UHMWPE without an antimicrobial LDPE. Fig. 6A shows bacteria accumulating on conventional UHMWPE fibers that do not contain antibacterial LDPE, while fig. 6B shows bacteria accumulating on antibacterial fibers according to one exemplary embodiment discussed herein. FIGS. 6A and 6B are both the results of GB/T20944.3-2008 tests at different bacterial loads. As shown, conventional UHMWPE fibers (e.g., glass slides 600A, 610A, 620A, and 630A) may accumulate a significant portion of bacteria that pass through the fibers and are then exposed to various environments that allow bacterial growth. In various embodiments, as shown, the amount of bacteria accumulated on the antimicrobial fibers may be significantly less than conventional UHMWPE fibers. As shown, the fiber environment therein allows 104In the case of Colony Forming Units (CFU)/milliliter (ml) of bacteria growth, slide 600B shows a significant reduction in bacteria accumulated by the antimicrobial fibers as compared to the conventional UHMWPE fibers shown inslide 600A. Such as where the fiber environment allows 103As shown in the case of CFU/ml, slide 610B shows a significant reduction in bacteria accumulated by the antimicrobial fibers compared to the conventional UHMWPE fibers shown inslide 610A. Such as where the fiber environment allows 102As shown in the case of CFU/ml, slide 620B shows a significant reduction in bacteria accumulated by the antimicrobial fibers compared to the conventional UHMWPE fibers shown inslide 620A. In which the fiber environment is allowed 102In another case of CFU/ml, theslide 630B showed a significant reduction of bacteria accumulated by the antimicrobial fibers compared to the conventional UHMWPE fibers shown in theslide 630A. In an exemplary embodiment, the reduction in bacterial accumulation of the antimicrobial fiber with 1% total weight of the antimicrobial LDPE may be about 96.6% as compared to a conventional UHMWPE fiber without the antimicrobial LDPE.
Embodiments of the present disclosure include antimicrobial fibers or fabrics that may be managed by, tested against, or otherwise associated with antibacterial-related standards. In some cases, these standards may be specified and/or enforced by a standards body or government agency. It will be apparent to those of ordinary skill in the art that these criteria may be updated or modified from time to change the requirements to meet the criteria (e.g., to reduce injuries or other accidents). As an example, fig. 6A and 6B show the results of the test. In addition, the antibacterial criteria may be updated in response to statistical analysis of the incident and/or in response to improved techniques. The antimicrobial fibrous structures described herein comprise a combination of different technologies to achieve enhanced bacterial resistance. Using a combination of techniques rather than simply using one technique may facilitate achieving multiple at least partially competing goals and/or balancing the performance of a given design. For example, the antimicrobial fibers can be configured to meet ASTM E2149 antimicrobial standards. When tested using the AATCC 100-. Furthermore, the antimicrobial fiber of one exemplary embodiment resulted in a reduction in E.coli by more than 99% according to ASTM 2149-2013 a.
Many modifications and other embodiments of the inventions set forth herein will come to mind to one skilled in the art to which these inventions pertain having the benefit of the teachings presented in the foregoing descriptions and the associated drawings. Therefore, it is to be understood that the inventions are not to be limited to the specific embodiments disclosed and that modifications and other embodiments are intended to be included within the scope of the appended claims. Although specific terms are employed herein, they are used in a generic and descriptive sense only and not for purposes of limitation.
Claims (20)
Translated fromChinesePriority Applications (3)
| Application Number | Priority Date | Filing Date | Title |
|---|---|---|---|
| CN201911202188.7ACN112877802A (en) | 2019-11-29 | 2019-11-29 | Antibacterial fiber |
| EP20208680.7AEP3828322B1 (en) | 2019-11-29 | 2020-11-19 | Anti-bacterial fibers |
| US17/105,046US12264417B2 (en) | 2019-11-29 | 2020-11-25 | Anti-bacterial fibers |
Applications Claiming Priority (1)
| Application Number | Priority Date | Filing Date | Title |
|---|---|---|---|
| CN201911202188.7ACN112877802A (en) | 2019-11-29 | 2019-11-29 | Antibacterial fiber |
Publications (1)
| Publication Number | Publication Date |
|---|---|
| CN112877802Atrue CN112877802A (en) | 2021-06-01 |
Family
ID=73497637
Family Applications (1)
| Application Number | Title | Priority Date | Filing Date |
|---|---|---|---|
| CN201911202188.7APendingCN112877802A (en) | 2019-11-29 | 2019-11-29 | Antibacterial fiber |
Country Status (3)
| Country | Link |
|---|---|
| US (1) | US12264417B2 (en) |
| EP (1) | EP3828322B1 (en) |
| CN (1) | CN112877802A (en) |
Citations (5)
| Publication number | Priority date | Publication date | Assignee | Title |
|---|---|---|---|---|
| US20070059347A1 (en)* | 2005-09-13 | 2007-03-15 | Mitsui Chemicals, Inc. | Antibacterial fiber assembly and production method and uses thereof |
| AU2008240809A1 (en)* | 2007-04-18 | 2008-10-30 | Basf Se | Antimicrobial plastics and coatings |
| KR20120122822A (en)* | 2011-04-30 | 2012-11-07 | (주)글로벌첼린지 | Preparation of ultra high molecular weight polyethlene fiber |
| CN109440211A (en)* | 2018-10-30 | 2019-03-08 | 浙江千禧龙纤特种纤维股份有限公司 | For producing the antibacterial mother liquor of antibacterial type ultra high molecular weight polyethylene fiber |
| CN109868518A (en)* | 2019-02-18 | 2019-06-11 | 浙江千禧龙纤特种纤维股份有限公司 | A kind of production method of antibacterial type ultra high molecular weight polyethylene fiber |
Family Cites Families (4)
| Publication number | Priority date | Publication date | Assignee | Title |
|---|---|---|---|---|
| EP1918306A3 (en)* | 2006-10-31 | 2008-05-14 | The University of New Brunswick | Antimicrobial and Bacteriostatic-Modified Polysaccharides |
| DK2294254T3 (en) | 2008-06-20 | 2013-03-11 | Dsm Ip Assets Bv | Ultra-high molecular weight polyethylene yarn |
| US10132006B2 (en)* | 2012-07-27 | 2018-11-20 | Honeywell International Inc. | UHMWPE fiber and method to produce |
| CN109468700A (en)* | 2018-10-31 | 2019-03-15 | 盐城优和博新材料有限公司 | A kind of manufacturing method of antibacterial high-strength polyethylene fibre |
- 2019
- 2019-11-29CNCN201911202188.7Apatent/CN112877802A/enactivePending
- 2020
- 2020-11-19EPEP20208680.7Apatent/EP3828322B1/enactiveActive
- 2020-11-25USUS17/105,046patent/US12264417B2/enactiveActive
Patent Citations (5)
| Publication number | Priority date | Publication date | Assignee | Title |
|---|---|---|---|---|
| US20070059347A1 (en)* | 2005-09-13 | 2007-03-15 | Mitsui Chemicals, Inc. | Antibacterial fiber assembly and production method and uses thereof |
| AU2008240809A1 (en)* | 2007-04-18 | 2008-10-30 | Basf Se | Antimicrobial plastics and coatings |
| KR20120122822A (en)* | 2011-04-30 | 2012-11-07 | (주)글로벌첼린지 | Preparation of ultra high molecular weight polyethlene fiber |
| CN109440211A (en)* | 2018-10-30 | 2019-03-08 | 浙江千禧龙纤特种纤维股份有限公司 | For producing the antibacterial mother liquor of antibacterial type ultra high molecular weight polyethylene fiber |
| CN109868518A (en)* | 2019-02-18 | 2019-06-11 | 浙江千禧龙纤特种纤维股份有限公司 | A kind of production method of antibacterial type ultra high molecular weight polyethylene fiber |
Also Published As
| Publication number | Publication date |
|---|---|
| US12264417B2 (en) | 2025-04-01 |
| US20210198814A1 (en) | 2021-07-01 |
| EP3828322A1 (en) | 2021-06-02 |
| EP3828322B1 (en) | 2024-03-27 |
Similar Documents
| Publication | Publication Date | Title |
|---|---|---|
| CN113597483B (en) | Cut-resistant polyethylene yarn, its production method, and protective articles produced therefrom | |
| KR102286437B1 (en) | artificial hair fiber | |
| JP6649395B2 (en) | Method for producing high-strength synthetic fiber and high-strength synthetic fiber produced therefrom | |
| CN104088031B (en) | Multi-functional nylon-6 fiber and manufacture method thereof | |
| TW201608069A (en) | Highly functional multifilament | |
| CN101501257A (en) | Cut-resistant yarn | |
| KR20170037392A (en) | Poly(ethyleneterephthalate) Yarn, Method for Manufacturing The Same, and Tire Cord Manufactured Using The Same | |
| KR0140074B1 (en) | Yarns made from core-seed filaments and preparation methods thereof | |
| KR101744257B1 (en) | method and device of manufacturing meta-aramid fiber for reduced shrinkage | |
| CN112877802A (en) | Antibacterial fiber | |
| KR20200083274A (en) | Polyethylene Multifilament Interlaced Yarn of High Tenacity and Method for Manufacturing The Same | |
| KR101858550B1 (en) | Manufacturing method of high strength fiber and high strength fiber manufactured thereby | |
| JP4504585B2 (en) | Yarn composed of polyolefin filament yarn and polyacetal filament yarn | |
| EP0958414A4 (en) | ||
| JP5794353B1 (en) | braid | |
| JPH0830283B2 (en) | Method for producing polyphenylene sulfide monofilament | |
| CZ20056A3 (en) | Process of spinning multifilament thread, fibrous yarn, polyester fibrous yarn and cord comprising the polyester fibrous yarn | |
| JP7583026B2 (en) | Fiber for artificial hair, head ornament product containing same and manufacturing method thereof | |
| KR102144201B1 (en) | Polypropylene filament elastic yarns, fabric thereof and manufacture method | |
| CN1200775A (en) | Making high filament count fine filament polyester yarns | |
| JP6772504B2 (en) | Braid made of high-performance polyethylene multifilament | |
| JPH02210018A (en) | Polyamide fiber for reinforcing v-belt | |
| US20030020190A1 (en) | Production of melt fused synthetic fibers using a spinneret | |
| JPH04327214A (en) | Conjugate fiber | |
| JPH04333618A (en) | Polyphenylene sulfide conjugate fiber |
Legal Events
| Date | Code | Title | Description |
|---|---|---|---|
| PB01 | Publication | ||
| PB01 | Publication | ||
| SE01 | Entry into force of request for substantive examination | ||
| SE01 | Entry into force of request for substantive examination | ||
| TA01 | Transfer of patent application right | ||
| TA01 | Transfer of patent application right | Effective date of registration:20250606 Address after:Delaware, USA Applicant after:OMSIGNAL Inc. Country or region after:U.S.A. Address before:new jersey Applicant before:HONEYWELL INTERNATIONAL Inc. Country or region before:U.S.A. |